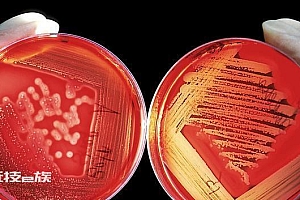

临近春节,苹果带来的惊喜也是接连不断,前天夜里官网悄悄上架了新款Mac mini和MacBook Pro,搭载全新的M2 Pro和M2 Max,不少网友表示压岁钱还没到手就已经没了。昨天夜里,苹果又给大家带来一份新年礼,是阔别许久的智能音箱产品HomePod。据了解,第一代HomePod发布于2017年,并于2021年宣布停产,但产品在二手平台的价格却没有下滑很多,甚至不降反升,可见苹果HomePod还是受到不少消费者的喜爱。
新上架的HomePod外形上与初代没有太大差别,不过内部配置发生了较大的改变,价格也下调了一点,从2799元变成了2299元,于2月3日发售。其实,苹果HomePod自发布以来,虽然受到的关注度极高,但并未掀起太大的波澜,影响力远远不如苹果的其他产品。更多人只是将其当做一款音质出众的蓝牙音箱,而非智能音箱,苹果想借此打开智能家居市场的愿景也并未实现。
(图源:苹果官方)
如今,苹果再次拿出一款价格相对亲民的HomePod,与HomePod mini一同完成中高端布局,结合苹果官网近日上线的全新的智能家居板块,是否意味着苹果准备认真搞智能家居?面对日薄西山的智能音箱市场,苹果与HomePod是否能力挽狂澜呢?
配置不升反降,苹果连牙膏都不挤了?
首先还是带着大家一起先了解一下新款HomePod,音箱依旧为圆润的造型设计,表面覆盖柔软纯色的织网,彰显出时尚优雅感,可以很好地融入不同家居风格,也让电子产品多了几分温暖的触感。今年依旧只有两种配色,一款为白色,而上一代的黑色也升级为午夜色。除了颜色上的改变,新款HomePod的升级主要放在芯片和声学系统上。
(图源:苹果官方)
初代HomePod搭载的是A8芯片,与iPhone 6同款,而新款HomePod则用上了S7芯片,也就是Apple Watch S7上所搭载的那枚芯片,基于A13处理器改造,在性能及算力等方面相比A8会有巨幅提升。与HomePod mini上所搭载的S5相比,S7的处理处理速度提升了近20%,在唤醒Siri进行语音操控,或连接智能家居等方面具有更流畅、迅速的响应。
新款HomePod内部还搭载了一枚U1超宽频芯片,将搭载有相同芯片的iPhone(iPhone 11系列及后续机型)靠近音箱,就会智能弹出歌曲推荐等信息,帮助你快速进行音乐的跨设备流转播放。
(图源:苹果官方)
音质表现方面,音箱内部搭载苹果定制研发的4英寸高振幅低音单元、五个波束成形高音单元组成的阵列以及四个低音校准麦克风等。同时,音箱还支持计算音频技术和空间感应技术,能根据被物体反射回来的声音判断是否靠近墙面,进而对音频进行实时调整。如果你恰巧财力雄厚,还可以购买两个HomePod并组成立体声,获得杜比全景声空间音频体验。
仅从硬件规格上讲,新款HomePod比初代还少了两个高音单元和两个麦克风,在音质表现以及远场语音识别精准度上,肯定会有一定的缩水。但有了性能更强的S7芯片和计算音频等技术的加入,能一定程度弥补硬件上的降级。至于实际体验有多大差异,目前还无法知晓,不过考虑到产品价格还便宜了500元,这样的配置缩水也可以接受。
(图源:苹果官方)
结合苹果这一举动进行大胆猜测,小雷觉得苹果应该是将HomePod的侧重点逐渐放在“智能”上,所以适当的弱化了其在声学系统上的性能,让它看起来更像是一款“智能音箱”,而非只是音质出众的“蓝牙音箱”。从表面上看,这或许是苹果在HomePod上开始摆烂,连牙膏都不愿意挤一点,但实则可能是苹果发展方向的转变,希望以更低的价格来推动HomePod普及,为苹果智能家居板块铺路。
HomePod 救不了苹果的智能家居梦
如今,全屋智能已经成为行业的大趋势,华为、百度、阿里等都在朝着这个大方向探索,美的、海尔等家电巨头也同样提供各种全屋智能解决方案,旨在帮助用户轻松打造全屋家电智能化体验。智能家居绝对是未来最具发展潜力的一个领域,苹果尽管尝试多年都没有太大的起色,但必然是不愿放弃这个市场的。官网家居板块的上线以及新款HomePod的发布,到底能不能帮助苹果在智能家居领域拿到更多的筹码呢?
就目前的形式来看,小雷觉得机会仍旧很渺茫,苹果在国内的智能家居梦并没那么容易就能实现。第一,智能家居对于多数人而言都是比较陌生的新鲜事物,很多人是抱着尝鲜的心态去体验产品,并不会一来就在这上面搞大投资,低价实用才是多数人选购智能家电的首要考虑因素。
(图源:苹果官方)
然而,苹果智能家居产品的价格都不便宜。一个灯泡就要126元,是其他竞品的两三倍。智能音箱HomePod更是卖到2299元,可以买10台小爱同学智能音箱,即便选择价格较低的HomePod mini,那也要749元。与国内其他品牌相比,苹果智能家居产品太高端了,价格上没有任何优势,并不利于产品普及扩大市场。不过,新款HomePod支持Matter协议,能够兼容其他品牌的产品,这对苹果扩大市场影响力有一定的帮助,就看消费者愿不愿意买单了。
第二,苹果目前还是选择通过HomePod来打开智能家居市场,或者这将成为苹果未来的控制中枢之一,通过对音箱下达指令来完成全屋家居控制。但是,智能音箱的浪潮已经开始褪去了,很多消费者发现智能音箱并没有自己想象中的那么好用,逐渐失去兴趣。如百度、天猫精灵等已不再更新智能音箱产品了,而是推出带屏幕且支持语音控制的智能屏。除此之外,欧瑞博还在智能开关上加入屏幕,想以此来充当全屋智能的控制中枢。
(图源:苹果官方)
依靠语音命令操控家电的方式逐渐被行业淘汰,视觉及触控可能才是未来的主流,苹果的布局显然又慢了一步。如果苹果Siri的智能化程度非常高,能将语音控制的体验做的很完美,或许能争取到一些优势。但实际情况是Siri的体验还远不如小爱同学,那还拿什么去追?所以,苹果想要依靠HomePod来打开国内智能家居市场,目前来看依旧是机会渺茫。国内的竞争太过激烈,产品迭代非常快,而苹果产品基本都是一年一更新,真的不一定能跟上市场的节奏。
在很多人的眼里,HomePod就是苹果布局智能家居领域的关键,但前两代产品却并未如愿帮助苹果打开市场。如今,新款HomePod虽然价格便宜了,但配置也缩水,我们不清楚是苹果有新的谋划,还是单纯摆烂不想搞。但可以确定的一点是,属于智能音箱的时代正在逐渐远去,价格更便宜的HomePod也很难帮助苹果实现智能家居梦了。苹果的下一步到底该往哪里走,可能只有苹果自己清楚,期待未来苹果可以拿出颠覆行业的产品或者idea,挽救其在智能家居领域的失利。
本文来自微信公众号“雷科技”(ID:leitech),作者:我不是奥特曼_。